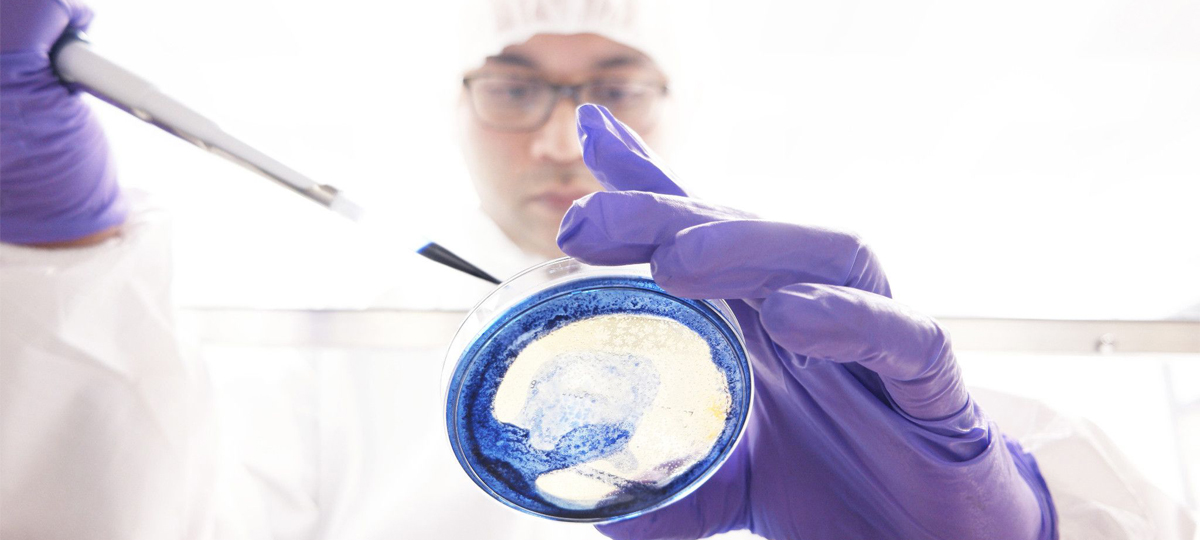

Microbial Solutions
|
Lucia Ceresa
How Ready are Your Cleanrooms for Annex 1 Updates?
Annex 1 updates: The impact on Microbial ID Strategy on cleanroom qualifications for pharma manufacturers
More than 10 years have passed since the last revision of the Annex 1 of the EU GMP Guideline for the manufacture of sterile medicinal products. With the revised document set for release later on this year, the updates significantly impact QC/QA and all laboratory activities, more so now than in previous revisions. This revision is intended to add detail and clarity, and provide global alignment of standards. So, this means that even though Annex 1 is a European document, if you’re a global drug manufacturer with customers in the EU you’ll want to see what’s in store for you and your lab. Here, we discuss some of the new requirements, and how CROs like Charles River can help streamline the qualification process.
While Annex 1 covers topics ranging from environmental monitoring to Quality Risk Management principles and introduction of modern technologies to the lab, this article focuses specifically on cleanroom qualifications and microbial identification strategies. That is, what should QC microbiologists know if they’re tasked with designing and qualifying a new cleanroom or re-qualifying an existing one? This is especially important for facilities falling into Grade A or B (corresponding to ISO 5 or 6) classification per criteria in table 1.
Table 1. Recommended limits for microbial contamination in operation (Annex 1 revision 2017)
| Grade | Air Sample cfu/m3 | Settle Plates (Diameter 90 mm) cfu/4 Hours (a) | Contact Plates (Diameter 55 mm) cfu/plate |
| A(b) | 1 | 1 | 1 |
| B | 10 | 5 | 5 |
| C | 100 | 50 | 25 |
| D | 200 | 100 | 50 |
a. 546 Individual settle plates may be exposed for less than 4 hours. Where settle plates are exposed for less than 4 hours the limits in the table should still be used, no recalculation is necessary. Settle plates should be exposed for the duration of critical operations and changed as required after 4 hours.
b. It should be noted that for grade A the expected result should be 0 cfu recovered; any recovery of 1 cfu or greater should result in an investigation.
The Annex 1 draft emphasizes the role of the QC microbiologist for all manufacturing processes. In terms of cleanroom qualifications, it specifically states that “processes and monitoring systems for sterile product manufacturing must be designed, commissioned, qualified, and monitored by personnel with appropriate process, engineering, and microbiological knowledge.”
Bringing up a new cleanroom requires a huge investment in money, time, and resources. Given its role in patient safety and product quality, there are extensive regulatory requirements surrounding its design and validation. Between recent revisions to some of these requirements in ISO 14644 and the proposed changes to Annex 1, will your performance qualification meet the new standard?
Performance qualification is absolutely essential for determining whether a cleanroom was adequately designed and built to prevent contamination of the products being manufactured under normal operating conditions, and requires a thorough microbiological analysis. A poor qualification increases risk to manufacturing, the environment, patient safety, and the company’s investment in the new facility.
Why are accurate microbial IDs important for cleanroom performance qualification?
During a performance qualification, it is not enough to just detect contamination. Bioburden counts need to be followed by identification. Understanding the flora in the cleanroom helps direct an appropriate cleaning strategy and determine where the contamination is coming from, along with what controls need to be added to protect the product. Risk assessments are an important part of qualifications, and an appropriate risk assessment cannot be made without an accurate microbial ID. Identification establishes a baseline for what flora is found in the cleanroom, which is critical for establishing alert and action limits. From this information, changes in the manufacturing environment can then be routinely assessed. The draft Annex 1 speaks extensively about the importance of trending data on a regular basis.
Moreover, cleanroom qualification is not a one-time event. Cleanrooms should be requalified periodically – including after any changes to equipment, facility, or processes. It is clearly stated in the reviewed Annex 1 guideline (5.29) that for grades A/B, “the maximum time interval for requalification is 6 months. For grades C and D, the maximum time interval for requalification is 12 months.” Requalification provides the opportunity to critically evaluate the microbiological data, and identifications during this process are just as important to assessing changes and risk to the product and patients.
What are the risks of failed or inaccurate IDs during a cleanroom performance qualification?
Microbial identification methods that are either inaccurate or cannot be reproduced during a performance qualification can lead to a false sense of control. An ensuing contamination would then cost additional time and money to remediate, both at the time of the qualification and possibly in the future. It would certainly mean delays in manufacturing, leading to potential drug shortages directly impacting patient health and safety and drawing unwanted attention by regulatory bodies. Since a new facility is under severe scrutiny by company executives, these undesirable outcomes can be very difficult to explain to management.
Table 2. Costs associated with a contamination event
| Issue | Potential Impact and Cost |
| Production interruption for alert | Up to USD 10,000 |
| Commercial impact if cleanroom is closed | Up to USD 1 billion in lost revenue - Loss of reputation - Drug shortages - Lost business to competitors - Fines |
| Failed production lot/scrap batch | Up to USD 1 million |
| QA investigation | Up to USD 60,000 |
| Remediation of facility and equipment | Up to USD 100,000 |
See references below for estimated figures
Check list for selecting a microbial ID partner
Careful consideration should be given when selecting a partner for microbial identification during a cleanroom qualification (and beyond). Here are the top questions that will point you in the right direction:
- Is the microbial ID lab ISO certified?
- Does the laboratory have capacity to process a large number of samples without delay?
- Can the ID lab offer fast turnaround times such as same day or one day if needed?
The answer you’re looking for is “Yes” on all points. Our Accugenix® services are designed for regulatory compliance, with
ISO certifications granted to our six global laboratory facilities. We release thousands of accurate identification results every day, with 99.6% on-time delivery rate. The turnaround times range from same day to five days, with all ID reports stored in a secure web portal. For more information about microbial identification services, check out www.criver.com/accugenix.
If you’d like to learn more about Annex 1 revisions, watch our recorded webinars on the topic:
Understanding the EU GMP Annex 1 Revisions and Addressing the Proposed EU GMP Annex 1 Changes. Your EM Program, and Micro QC Operations.
References
EU Annex 1Revision, December , 20th, 2017:
https://ec.europa.eu/health/human-use/quality/developments/pc_2017_12_sterile_medicinal_products_en
EU Annex 15; Qualification and Validation, https://ec.europa.eu/health/sites/health/files/files/eudralex/vol-4/2015-10_annex15.pdf
ISO 14644-1:2015, Cleanrooms and associated controlled environments -- Part 1: Classification of air cleanliness by particle concentration; https://www.iso.org/standard/53394.html
Westman, David. (2017, April 12). Cost and Impact of a bioburden incident. Retrieved 02Jan 2019 from https://www.cytivalifesciences.com/en/us/news-center/cost-and-impact-of-a-bioburden-incident-10001




